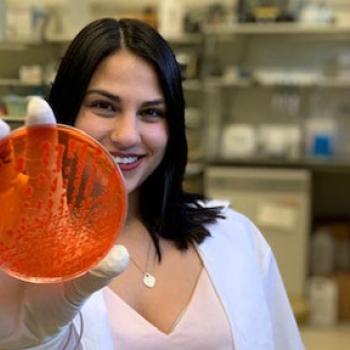

Ohio University offers master's and doctoral programs in biological sciences, with concentrations available in (i) Ecology and Evolutionary Biology, (ii) Integrative Physiology and Neuroscience, and (iii) Cell, Developmental and Microbiology.
-
Ph.D. in Biological SciencesThe Biological Sciences Department at Ohio University offers a graduate program that includes faculty from both Biological Sciences and Biomedical Sciences (Ohio University Heritage College of Osteopathic Medicine).
-
M.S. in Biological SciencesFaculty and graduate students conduct research on a wide array of biological topics spanning from molecules to ecosystems, and from basic to applied research.
-
Graduate Certificate in Conservation BiologyThe program in Conservation Biology offers an interdisciplinary graduate certificate in conservation biology that involves contributions from anthropology and sociology, biological sciences, economics, geography, geology, history, and political science.
Explore Faculty Research Areas
The Biological Sciences graduate program includes faculty from both Biological Sciences (BIOS – College of Arts and Sciences) and Biomedical Sciences (BMS - Ohio University Heritage College of Osteopathic Medicine). Faculty and graduate students conduct research on a wide array of biological topics spanning from molecules to ecosystems, and from basic to applied research.
Applicants to the Biological Sciences graduate program are required to list three potential Graduate Faculty Mentors. See the link below for a list of active graduate research faculty and for more information on their research interests.
-
Biology Students Make Significant Strides in New Way to Address ObesityIn a recent study, biology graduate students Hsuan-Chih Kuo and Zachary LaRussa found that supplementing a protein naturally produced in the body could potentially combat weight gain and improve metabolic health in patients with obesity.
-
Cassandra Thompson shows danger to frogs from pesticide, points to a solutionCassandra Thompson's research highlights the need to understand the tradeoffs of using pesticides on invasive species and the effects on vulnerable species such as amphibians.
-
Biology Grad Students Place in Three Minute Thesis CompetitionProthama Manna took 2nd Place for "Zoo gone wild - Predicting the Fate of the Invasive Hippo Population," and Julia Tennant took 3rd Place and People's Choice for her talk on "Regulatory Role of sRNA, Teg41 on Staphylococcus aureus pathogenesis."
-
Students enjoy diving into freshwater fish biology research in the Morris LabStudents in the Morris LabA biology lab filled with thousands of freshwater fish from Mexico provides a hands-on setting for Ohio University students to examine how tiny, colorful swordtail fish are evolving and adapting.
-
Donald MIles collaborates on paper on evolution of mating systemsA new model for the evolution of mating systems focuses instead on social interactions driven by genetically determined behaviors, and how competition among different behavioral strategies plays out.
-
Notable Alumni | Aiden Shearer Developed First Genetic Test for DeafnessAlumnus Aiden “Eliot” Shearer developed the first genetic test panel for deafness OtoSCOPE®, new technology that has revolutionized the understanding of human hearing loss.